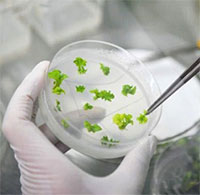

Công trình khoa học
Công trình khoa học
Các công trinh nghiên cứu khoa học nổi tiếng, những công trình khoa học nổi tiếng trên thế giới sẽ giúp bạn đọc có được thông tin mới nhất về những công trình nổi tiếng này

Lò phản ứng hạt nhân lớn nhất châu Âu đi vào hoạt động
Lò phản ứng hạt nhân lớn nhất châu Âu tiến vào giai đoạn sản xuất thường xuyên ở Phần Lan chỉ vài giờ sau khi Đức đóng cửa 3 lò phản ứng cuối cùng.
Đăng ngày: 18/04/2023

Quá trình xây dựng tòa nhà nghiên cứu mới ở châu Nam Cực
Tòa nhà mới rộng 4.500m2, dự kiến hoàn thành vào năm 2025, đang được gấp rút thi công trong thời tiết cực lạnh, gió lớn, tuyết và sông băng dịch chuyển trên một lục địa không dễ tiếp cận.
Đăng ngày: 15/04/2023

Nhà máy nhiệt điện mặt trời máng cong lớn nhất Trung Quốc
Khi chạy hết công suất, nhà máy Wulate Zhongqi ở khu tự trị nội Nội Mông có thể đáp ứng nhu cầu sử dụng điện của 300.000 hộ gia đình.
Đăng ngày: 15/04/2023
Trung Quốc thành lập chuỗi ngân hàng hạt giống để lưu trữ nguồn gene thực vật
Để bảo vệ tính đa dạng loài và an ninh lương thực, Trung Quốc đang đẩy mạnh xây dựng các ngân hàng hạt giống lưu trữ nguồn gene thực vật.
Đăng ngày: 10/04/2023

Các nhà khoa học nghiên cứu xây dựng tòa nhà gỗ 10 tầng có thể chịu động đất
Các nhà nghiên cứu xây dựng một tòa nhà bằng gỗ 10 tầng để kiểm tra khả năng chịu động đất của công trình.
Đăng ngày: 10/04/2023

Sant'Antonio - Nhà máy thủy điện dưới lòng đất đầu tiên trên thế giới
Nhà máy thủy điện Sant'Antonio ẩn mình giữa những ngọn núi Alpine bao quanh thị trấn Bolzano, Ý, là một kỳ quan kỹ thuật dưới lòng đất.
Đăng ngày: 10/04/2023

Khám phá phòng thí nghiệm sâu 2.500m dưới nước
Phòng thí nghiệm đại dương Laboratoire Sous-marin Provence Méditerranée (LSPM) nằm cách bờ biển thành phố Toulon (Pháp) 40km, ở độ sâu 2.500m.
Đăng ngày: 05/04/2023

Dự án siêu pin có thể cấp điện cho 80.000 hộ gia đình
Tập đoàn năng lượng Shell của Anh đã ký thỏa thuận lắp đặt một hệ thống pin khổng lồ có công suất lên tới 200 MW ở Australia.
Đăng ngày: 05/04/2023

Trung Quốc sắp hoàn thành đập thủy điện ở độ cao 5.000m
Nhà máy thủy điện Maerdang nằm ở thượng nguồn sông Hoàng Hà có tổng công suất lắp đặt khoảng 2,2 triệu kW.
Đăng ngày: 26/03/2023

Trung Quốc nghiên cứu phát triển kính viễn vọng săn "hạt ma" neutrino dưới nước
Các nhà khoa học Trung Quốc đang nghiên cứu phát triển một kính viễn vọng khổng lồ để quan sát hạt neutrino từ dưới hồ hoặc biển sâu.
Đăng ngày: 24/03/2023

Khám phá cơ sở đông lạnh thi thể người để chờ hồi sinh Cryonics Institute
Hàng nghìn người đã đăng ký để được đông lạnh thi thể sau khi chết với hy vọng họ có thể sống lại trong tương lai.
Đăng ngày: 21/03/2023

Khám phá ngân hàng hạt giống lớn nhất thế giới
Ngân hàng Hạt giống Thiên niên kỷ (MSB) là một trong những ngân hàng hạt giống lớn nhất thế giới và là nơi lưu trữ, bảo tồn hàng ngàn loài thực vật hoang dã quý hiếm.
Đăng ngày: 18/03/2023

Dự án xây 25 tòa nhà chọc trời chống bão cát ở Dubai
Các tòa nhà trong dự án có cấu trúc chính gồm hai hốc sâu để hấp thụ hạt cát, đồng thời lắp đặt pin cát để tích trữ năng lượng.
Đăng ngày: 16/03/2023

Top 7 siêu dự án đến từ tương lai sắp được các đại gia dầu mỏ Ả Rập trình làng
Những công trình này có thể làm choáng ngợp bất cứ ai chiêm ngưỡng bởi mức độ xa hoa và hoàng tráng không tưởng.
Đăng ngày: 11/03/2023

Hai dự án khổng lồ của Arab Saudi: Công nghệ đủ cả, hoành tráng đến khó tin!
Không những sở hữu kiến trúc độc đáo, hai siêu dự án này của Arab Saudi còn được tích hợp nhiều tiến bộ công nghệ và có tính bền vững.
Đăng ngày: 08/03/2023

Trung Quốc lắp kính viễn vọng lớn ở độ cao 4.520m
Một kính viễn vọng quang học đường kính 1,9m với độ phân giải cực cao sắp được lắp đặt trên cao nguyên Pamir để thám hiểm không gian sâu.
Đăng ngày: 28/02/2023
Tiêu điểm


